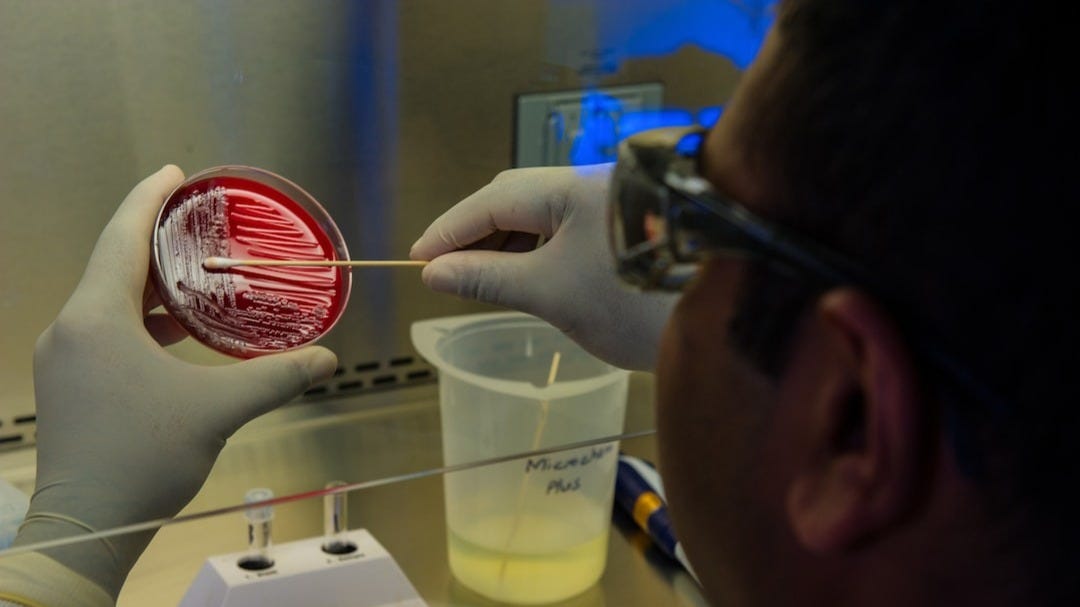
Promising Clinical Results Announced For New Drug Ibezapolstat

Promising Clinical Results Announced For New Drug Ibezapolstat
Acurx's Ibezapolstat Shows Promising Results in Phase 2b Clinical Trial: What You Need to Know.
Disclaimer: This post includes affiliate links. If you purchase anything through these affiliated links, the author/website may earn a commission.
In the world of pharmaceuticals and healthcare, a new development has emerged that could have significant implications for patients suffering from Clostridioides difficile infection (CDI). Acurx Pharmaceuticals has announced positive data from its Phase 2b clinical trial for the drug Ibezapolstat, a CDI treatment.
Acurx Pharmaceuticals, a publicly traded company with the ticker symbol $ACXP, is a clinical-stage biopharmaceutical company focused on developing novel therapies for bacterial infections. The company's lead product candidate, Ibezapolstat, is being developed as a potential first-in-class treatment for CDI.
CDI is a significant health concern, affecting nearly half a million people in the United States alone each year and causing approximately 29,000 deaths. The infection typically occurs in people who have used antibiotics and are in medical care settings. Current treatments can be ineffective and often result in recurrent infections.
Ibezapolstat's positive trial data could potentially change the landscape of CDI treatment. The drug has shown a lower rate of recurrence, thus reducing the risk of repeated infections. Additionally, its impact on the gut microbiome could help restore healthy bacteria, which is essential to prevent future infections.
However, it's important to note that these results are preliminary and further testing is required to confirm these findings. The next step for Acurx is to proceed with a Phase 3 clinical trial, which will involve a larger number of patients and further evaluate the drug's safety and efficacy.
In conclusion, the positive Phase 2b clinical trial results for Ibezapolstat represent a significant milestone for Acurx Pharmaceuticals. If successful in further trials, this groundbreaking drug could offer a new, more effective treatment for CDI, impacting countless lives worldwide.
This development is not only crucial for those directly affected by CDI but also for anyone invested in the healthcare industry or the stock market. Acurx's progress could potentially influence the company's market value and future growth prospects.
Sponsorship Disclosure: The author/website does not has an affiliate relationship with Acurx Pharmaceuticals.
As an investor it's important to stay updated with major news. Get real-time stock market alerts and research by creating an account here.
Sources: